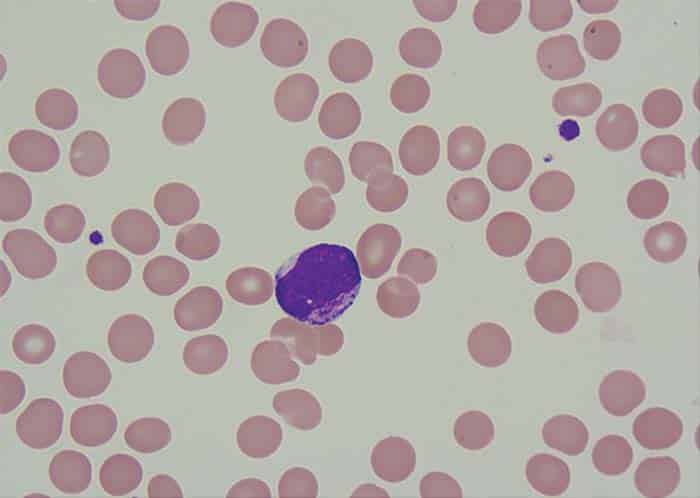

Reporte de caso:
From: Asociación de Patología Molecular (AMP) en la publicación CAPToday 2024 issues (1)

Definiciones:
Leucemia Mieloide Aguda: La leucemia mieloide aguda (AML) es un tipo de cáncer que afecta las células mieloides en la médula ósea. A diferencia de muchos otros tipos de cáncer, la AML no se clasifica por etapas como la mayoría. En cambio, se categoriza según subtipos y otros factores pronósticos.
Hiperdiploidia: Presencia de uno o más cromosomas o segmentos cromosómicos ganados respecto al estado normal (nótese la diferencia con «poliploide»). Dependiendo del grado de ploidía se puede definir estado hiperhaploide, hiperdiploide, hipertriploide, etc. Su origen no esta claramente definido, pero tiene alta relación con las Leucemias, espacialmente linfoblásticas. el origen de dichos mecanismos podía suceder en el momento en que la célula se divide: la mitosis, un proceso celular que controla la distribución equitativa del material genético, ya duplicado y compactado previamente en los cromosomas, y los reparte en dos células ‘recién nacidas’.
Deleción: es un tipo de mutación que implica la pérdida de uno o más nucleótidos de un segmento de ADN. Una deleción puede implicar la pérdida de cualquier número de nucleótidos, desde un solo nucleótido hasta una parte completa de un cromosoma.
Descripción del caso:
Varón de 87 años con antecedentes clínicos de hipertensión arterial y síndrome del seno enfermo que presentó una historia de un mes de fiebre, debilidad generalizada y pérdida de peso. No había linfadenopatía ni hepatoesplenomegalia en la exploración física. Se realizó un examen de médula ósea para evaluar la presencia de citopenias.
Los siguientes fueron los hallazgos de conteo celular en sangre periférica:
- Hemoglobina: 9.0 g/dL
- Hematocrito 27.0 %
- Leucocitos: 1920 × mm3
- Neutrófilos: 230 × mm3
- Plaquetas: 82000 mm3
En el extendido de sangre periférica se evidencia 21% de blastos. Adicionalmente se observa aniso – poiquilocitosis, macrocitosis y policromatófila en eritrocitos y trombocitopenia.
El aspirado de médula ósea mostró un 24 por ciento de células blásticas en la población total de células nucleadas no eritroides. Los blastocitos fueron de tamaño mediano a grande, con citoplasma moderadamente abundante que contenía gránulos rosados, cromatina nuclear abierta y nucléolos prominentes (Fig. 1).
En el fondo se observó hematopoyesis normal. Muestra de características hipercelular y mostraba infiltración intersticial con células blásticas. El inmunofenotipado de las células blásticas mediante citometría de flujo mostró reactividad a CD13, CD33, MPO citoplasmático, hla-dr, CD117, y y CD34. El análisis citogenético de la médula ósea se reportó como 52~58, XY, add(6)(q27)[16]/46,XY[04]. Se obtuvieron los siguientes cromosomas: 1, 2, 6, 8, 9, 11, 13, 16, 18, 20 y 22 (Fig. 2). Los ensayos FISH para la deleción 5q y la trisomía 8 fueron positivos (Figs. 3a y 3b). No se detectaron mutaciones en NPM1, FLT3-ITD y D835 mediante PCR convencional. El caso fue diagnosticado como leucemia mieloide aguda. Hasta el momento, el paciente ha recibido un ciclo de quimioterapia con azacitidina; Venetoclax se mantuvo después de la primera dosis debido a niveles anormales de creatinina sérica.

Discusión:
Discusión. En este informe se describe un caso de LMA con hiperdiploidía, que no se define específicamente como un subtipo de LMA en la quinta edición de la OMS de 2022 ni en la Clasificación de Consenso Internacional (ICC). El cariotipo hiperdiploide se define como un tumor mayor de 49 cromosomas. La hiperdiploidía es un fenómeno inusual en la LMA, con una incidencia reportada en la literatura de menos del dos por ciento de los casos de LMA(2). Los cromosomas comúnmente involucrados son la trisomía 8, 21 y 22, que se encuentran principalmente en la LMA de novo. Iyer, et al., informaron una tasa de remisión baja y una supervivencia corta en este grupo(3), mientras que Shetty, et al., informaron una tendencia menor de mejor resultado en comparación con la LMA con citogenética compleja(2). Sin embargo, Chilton, et al., sugirieron que estos pacientes no se clasificaran en un grupo de pronóstico adverso por defecto(4). Aquellos con características citogenéticas adversas específicas, como la monosomía 5 o 5q- y la monosomía 7 o 7q-, pueden asignarse a un grupo de riesgo adverso. Aquellos con solo incremento numérico se pueden clasificar como de riesgo intermedio.
La deleción del brazo largo del cromosoma 5 tiene una implicación pronóstica favorable en el síndrome mielodisplásico, pero una implicación desfavorable en la LMA. A menudo implica la pérdida de material genético, lo que afecta a genes críticos involucrados en la hematopoyesis y la regulación del ciclo celular. La deleción 5q fue detectada por FISH pero no por citogenética convencional en este paciente. Las deleciones crípticas, que pueden no ser evidentes en el análisis citogenético estándar, pueden plantear desafíos diagnósticos, pero se reconocen cada vez más con técnicas genómicas avanzadas. Estas deleciones se asocian con distintas implicaciones clínicas y pronósticas, que influyen en el curso de la enfermedad y en los resultados del tratamiento. La identificación de deleciones crípticas de 5q es crucial para la estratificación del riesgo, lo que podría guiar las decisiones terapéuticas y posiblemente adaptar las estrategias de tratamiento, como el uso de nuevas terapias dirigidas(5). A pesar de albergar este cambio cromosómico desfavorable, nuestro paciente inicialmente respondió bien a la azacitidina y mostró una mejoría en sus recuentos sanguíneos con la eliminación de las células blásticas en la sangre periférica.
Conclusión:
La importancia pronóstica exacta de la hiperdiploidía en las neoplasias mieloides malignas es indeterminada. Allanando el camino a seguir, la información proporcionada en el estudio actual contribuye a ayudar potencialmente a predecir el resultado de pacientes con anomalías similares y a construir el repositorio global de tales cambios genéticos inusuales.
No olvides suscribirte al Newsletter para estar mejor informado
Notas:
- AMP case report: Acute myeloid leukemia with hyperdiploidy – CAP TODAY (captodayonline.com)
- Shetty A, Cortes JE, Ravandi F, et al. Hyperdiploidy in AML: outcomes of acute myelogenous leukemia (AML) patients (pts) with a hyperdiploid karyotype. J Clin Oncol. 2014;32(15)(suppl):7088.
- Iyer RV, Sait SNJ, Matsui S, et al. Massive hyperdiploidy and tetraploidy in acute myelocytic leukemia and myelodysplastic syndrome. Cancer Genet Cytogenet. 2004;148(1):29–34.
- Chilton L, Hills RK, Harrison CJ, Burnett AK, Grimwade D, Moorman AV. Hyperdiploidy with 49–65 chromosomes represents a heterogeneous cytogenetic subgroup of acute myeloid leukemia with differential outcome. Leukemia. 2013;28(2):321–328.
- Rea B, Aggarwal N, Yatsenko SA, Bailey N, Liu YC. Acute myeloid leukemia with isolated del(5q) is associated with IDH1/IDH2 mutations and better prognosis when compared to acute myeloid leukemia with complex karyotype including del(5q). Mod Pathol. 2020;33(4):566–575.


Deja un comentario